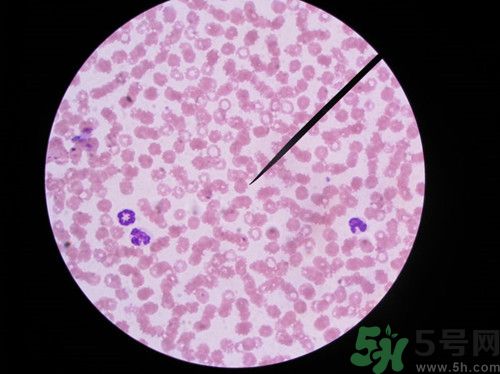
布魯氏桿菌病能治好嗎?布魯氏桿菌病傳播途徑有哪些

歡迎您,來到5號網(wǎng)!
時間:2016-05-29 10:29:08 編輯:本站整理 620
布魯氏桿菌病是一種傳染病,其中以山羊、綿羊等最容易感染,那么布魯氏桿菌病到底能不能治好呢?它的傳播途徑還有哪些呢?下面來為大家詳細介紹下!
能治好
全稱布魯士桿菌病由布氏桿菌引起的人畜共患的急、慢性傳染病。又稱馬耳他熱或波狀熱。
人以長期發(fā)熱,多汗,關節(jié)痛,睪丸炎,卵巢炎為特征.本病流行廣泛,幾乎遍布世界各地.我國的內蒙古,東北,西北等地區(qū)的牧區(qū)該病曾一度流行,其他北方地區(qū)也有散發(fā).近幾年由于養(yǎng)殖業(yè)發(fā)展迅猛,該病的發(fā)病率在我國有所上升.人感染布病后,潛伏期一般為7~60天,平均2周.少數(shù)患者可長達數(shù)月或1年以上.人患本病后,臨床表現(xiàn)復雜多變,癥狀各異,輕重不一,呈多器官病變或局限某一局部.臨床上一般分為急性期和慢性期二型.
如果發(fā)病在半年以內,可以采用抗菌素聯(lián)合治療,推薦使用利福平(0.3克/次,一日兩次,口服)、強力霉素(0.2克/日,一次頓服),三周一個療程,間歇7天,再用藥一個療程,可以在醫(yī)生指導下加用鏈霉素。治療的同時,注意藥品的禁忌癥和不良反應。
如果發(fā)病超過了半年,就會轉為慢性布病。治療應該采用中西醫(yī)結合療法,如果出現(xiàn)急性期臨床癥狀,可采用上述抗菌治療方案。中醫(yī)應辯證施治,最好找有經(jīng)驗的中醫(yī)大夫診治。
治療期間注意休息,加強營養(yǎng)。一定要足量全程用藥,以防復發(fā)。
布病主要傳染源是患布病的家畜以及患布病的嚙齒類動物,如羊、牛、豬、鹿、馬、駱駝、狗、鼠、家兔、貓等。目前,在我市以羊為主要傳染源。
1、經(jīng)皮膚粘膜接觸感染:從事接產、飼養(yǎng)、放牧、皮毛加工、屠宰、擠奶等職業(yè)的人員可因直接接觸病畜的流產物、乳、肉、內臟、皮毛等污染物,或間接接觸被病畜污染的水源、土壤、草場、工具等而感染。
相關文章
熱門文章
5H跟帖
最熱標簽
精選文章
美容養(yǎng)生醫(yī)療母嬰
猜你喜歡
網(wǎng)站簡介|網(wǎng)絡營銷|法律聲明|友情鏈接|聯(lián)系我們|意見反饋
Copyright ? 2012 - 2015 5h.com All Rights Reserved 5號健康網(wǎng)版權所有 鄂ICP備15005143號-3
提示:本站信息僅供參考,不能作為診斷及醫(yī)療的依據(jù);請謹慎參閱,本站不承擔由此引起的法律責任。本網(wǎng)站敬告網(wǎng)民:身體若有不適,請及時到醫(yī)院就診。
所有文章來自互聯(lián)網(wǎng) 如有異議 請與本站聯(lián)系 本站為非贏利性網(wǎng)站 不接受任何贊助和廣告
網(wǎng)友評論僅供其表達個人看法,并不表明5h立場。